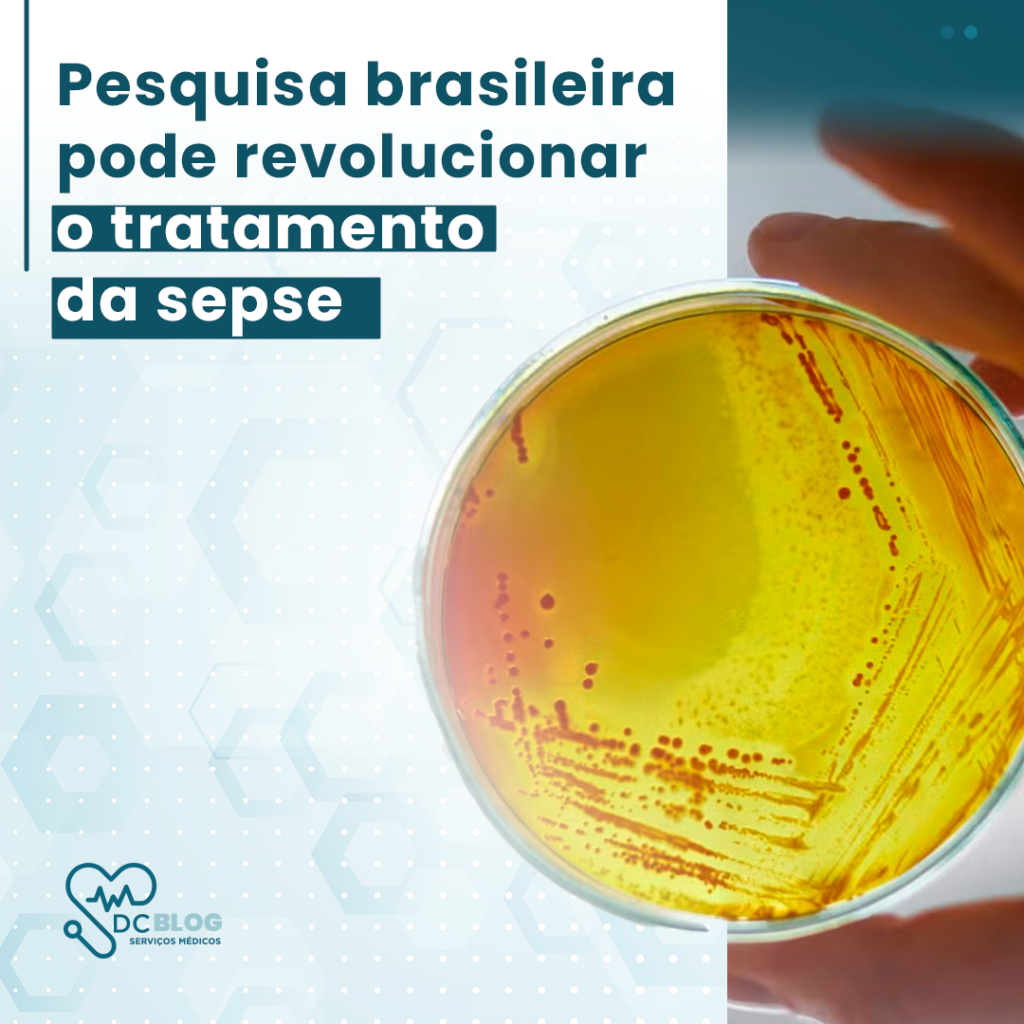

A ciência brasileira está à beira de um avanço significativo no combate à sepse, uma das maiores causas de mortalidade no mundo, responsável por cerca de 11 milhões de mortes por ano. Uma pesquisa inovadora conduzida por um estudante carioca de graduação em Ciências Biológicas promete abrir novas possibilidades para o tratamento e prevenção dessa condição, com potencial para o desenvolvimento de uma vacina inédita e de medicamentos altamente eficazes.
O que é Sepse e por que é tão grave?
A sepse é uma resposta inflamatória severa do organismo a infecções, que pode evoluir para falência de múltiplos órgãos. Com cerca de 50 milhões de casos registrados por ano no mundo, a sepse é uma das maiores causas de internação e readmissão hospitalar, representando um desafio significativo para os sistemas de saúde. No Brasil, a taxa de mortalidade por sepse é de 60%, muito superior aos índices de países desenvolvidos, onde gira em torno de 20%.
A Descoberta Inovadora
O estudante, cuja identidade é mantida em sigilo, iniciou sua pesquisa por curiosidade em um laboratório na faculdade e acabou descobrindo um mecanismo inovador sobre como a bactéria Staphylococcus aureus se prolifera em ambiente hospitalar, agravando quadros de sepse. Sua pesquisa identificou uma anomalia nos cílios da bactéria que atuam como “antenas”, captando quando os antibióticos estão atacando e estimulando a proliferação de novos patógenos.
A partir dessa descoberta, o estudo segue para o desenvolvimento de uma vacina e novos antibióticos, com o objetivo de interromper essa comunicação bacteriana e impedir a progressão da sepse.
Reconhecimento e Próximos Passos
A pesquisa foi apresentada à Fiocruz, onde chamou a atenção de cientistas renomados, e já está registrada na Organização Mundial da Saúde (OMS) para evitar plágio e garantir o reconhecimento internacional. Com a fase de testes laboratoriais prevista para começar em breve, a próxima etapa será a aprovação do Ministério da Saúde e o início dos ensaios clínicos, que envolvem testes em animais e humanos. A previsão é que a vacina possa ser desenvolvida em até três anos, enquanto medicamentos podem chegar ao mercado antes.
A Importância de Investir na Ciência Brasileira
Esse avanço mostra a importância de valorizar e apoiar a pesquisa científica no Brasil. Além de contribuir para a saúde pública global, a pesquisa destaca o potencial dos cientistas brasileiros e a relevância de termos soluções locais para grandes problemas de saúde. O desenvolvimento de uma vacina e medicamentos com patente brasileira não só reforça a soberania científica, mas também reduz a dependência de importações, tornando o acesso a tratamentos mais ágil e eficiente.
Impacto Global e Esperança para o Futuro
Com cerca de 1 a cada 5 mortes no mundo associada à sepse, qualquer avanço significativo no tratamento pode salvar milhões de vidas. O sucesso dessa pesquisa promete não apenas beneficiar pacientes no Brasil, mas também impactar o cenário global da saúde. A expectativa é que, com a descoberta e validação científica, o tratamento possa ser incorporado ao Sistema Único de Saúde (SUS), garantindo acesso para quem mais precisa.